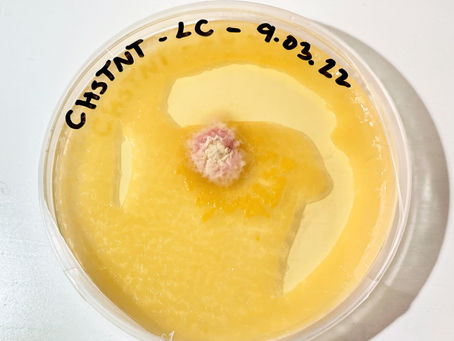
Sometimes contamination is more exciting than the mushrooms themselves.

top of page


Is it safe to grow mushrooms at home?
I am often asked if it is safe to grow mushrooms at home. The simple answer is yes! Mushrooms drop spores which are very small and easily...

The future is fungi
Mar 15, 20221 min read

Sometimes contamination is more exciting than the mushrooms themselves.
When doing mycelium transfers on agar dishes it is most important that the area used is impeccably clean, without a laminar flow hood...

The future is fungi
Mar 15, 20221 min read


The Beginnings of a Fungi Future
Over the last couple of years, I have found myself questioning how the products I design can be more sustainable. This has led to an...

annesofiebundell
Mar 14, 20221 min read
bottom of page